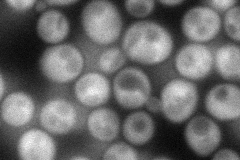
YNL231C
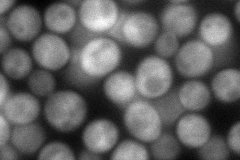
YNL231C
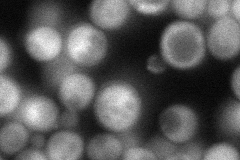
YNL231C
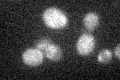
YNL231C
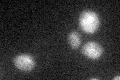
YNL231C

View description
Phosphatidylinositol transfer protein (PITP) controlled by the multiple drug resistance regulator Pdr1p, localizes to lipid particles and microsomes, controls levels of various lipids, may regulate lipid synthesis, homologous to Pdr17p
Localization:
Intensity:
Fold change:
Significance:
-
C’ GFP library in SD

cytosol18.8 -
N' NOP1pr-GFP in SD
cytosol104.63 -
N' TEF2pr-mCherry in SD
cytosol135.584 -
N' NATIVEpr-GFP in SD
cytosol,punctate69.5125 -
N' TEF2pr-VC and Cyto-VN in SD

#N/A0 -
C’ GFP library in SD+DTT

cytosol19.421.03No -
C’ GFP library in SD+H2O2
cytosol22.891.21No -
C’ GFP library in Starvation Media
cytosol25.771.36No -
C’ GFP library on the background of Pup2-DaMP

N/A -
C’ GFP library on the background of CCT mutant

N/A0N/AYes
